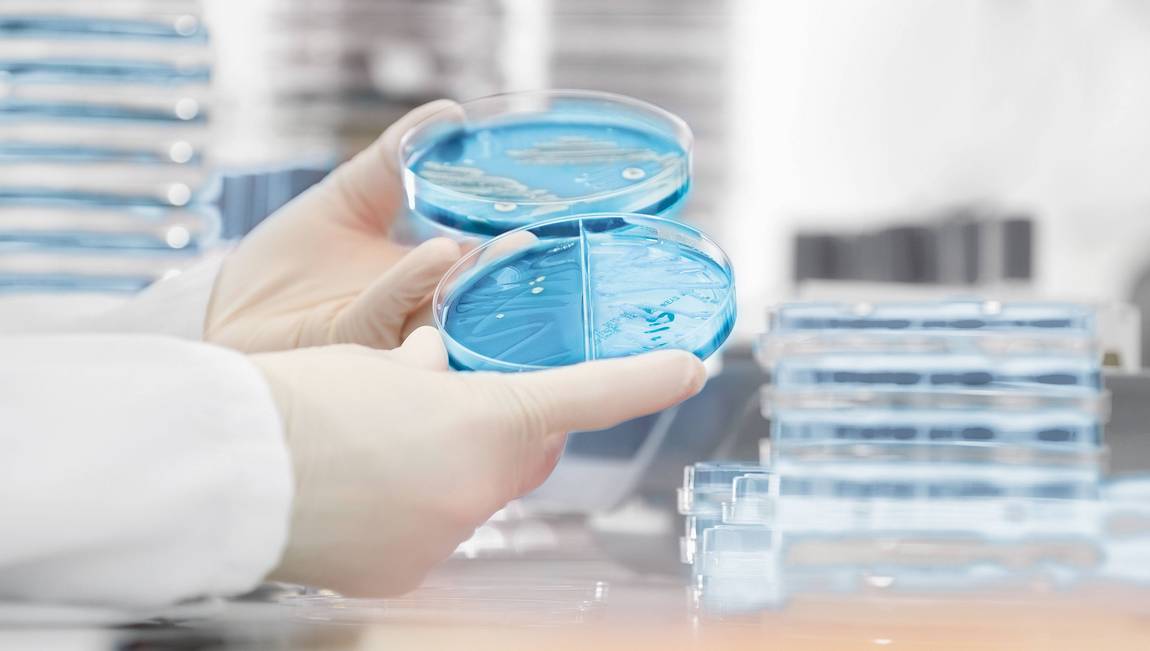

Befundauskunft
Labormedizin
Telefon 0551 85 20 1060

Labormedizin
Telefon 0551 85 20 1060

Mikrobiologie
Telefon 0551 30 750 531
Telefon 0551 85 20 1065 (Labor)
Telefon 0551 85 20 1064 (Mikrobiologie)

Telefon 0800 92 47 278

Telefon 0551 37 10 64

Telefon 0551 85 20 7430

Telefon 0800 589 05 06

Telefon 0551 85 20 1457

Telefon 040 33 44 11-99112

Telefon 0800 589 05 06
